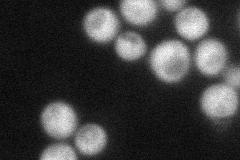
YPL017C
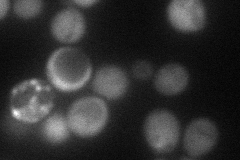
YPL017C
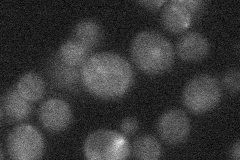
YPL017C
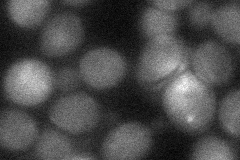
YPL017C
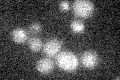
YPL017C

View description
Microtubule associated protein; regulates microtubule dynamics; required for accurate meiotic chromosome segregation; null mutant displays large budded cells due to delayed mitotic progression, increased levels of spontaneous Rad52 foci
Localization:
Intensity:
Fold change:
Significance:
-
C’ GFP library in SD

below threshold16.49 -
N' NOP1pr-GFP in SD
cytosol46.768 -
N' TEF2pr-mCherry in SD
cytosol45.3916 -
N' NATIVEpr-GFP in SD
below threshold20.1678 -
N' TEF2pr-VC and Cyto-VN in SD
cytosol34.0895 -
C’ GFP library in SD+DTT

cytosol19.171.16No -
C’ GFP library in SD+H2O2

cytosol15.740.95No -
C’ GFP library in Starvation Media
cytosol13.270.8No -
C’ GFP library on the background of Pup2-DaMP

below threshold -
C’ GFP library on the background of CCT mutant

below threshold17.67471.07127No
